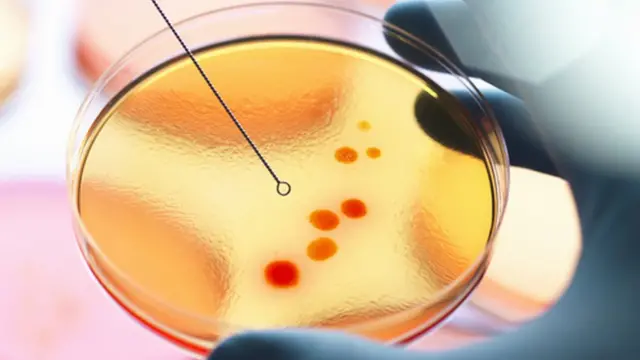
கொரோனா வைரஸ்

தமிழ்நாட்டில் 14 மாவட்டங்களில் அதிகரித்த கொரோனா வைரஸ் பாதிப்பு - 3வது அலையின் தொடக்கமா?

பட மூலாதாரம், Getty Images
- எழுதியவர், ஆ விஜயானந்த்
- பதவி, பிபிசி தமிழுக்காக
- பிரசுரிக்கப்பட்டது
கொரோனா தொற்று படிப்படியாக குறைந்து வரும் நேரத்தில் தமிழ்நாட்டில் 14 மாவட்டங்களில் கணிசமாக உயர்ந்து வருவது அதிர்ச்சியை ஏற்படுத்தியுள்ளது. `மூன்றாம் அலையின் தொடக்கமாகவும் இது இருக்கலாம்' என்கின்றனர் மருத்துவ வல்லுநர்கள். என்ன நடக்கிறது?
கொரோனா தொற்றின் இரண்டாம் அலையால் இந்தியா முழுவதும் கடும் பாதிப்புகள் ஏற்பட்டன. நாளொன்றுக்கு 4 லட்சம் என்ற அளவில் இருந்த கொரோனா தொற்றின் வேகம் தற்போது 45,000 என்ற அளவில் உள்ளது.
வியாழக்கிழமை நிலவரப்படி தொற்று எண்ணிக்கை 45,951 என்ற அளவில் பதிவாகியுள்ளது.
அதேபோல், தமிழ்நாடு சுகாதாரத்துறை கடந்த புதன்கிழமை வெளியிட்ட தகவலில், 4,506 பேருக்கு தொற்று உறுதி செய்யப்பட்டுள்ளதாகத் தெரிவித்தது.
மேலும், 113 பேர் உயிரிழந்துள்ளதாகவும் 5,537 பேர் குணமடைந்து வீடு திரும்பியதாகவும் கூறப்பட்டுள்ளது. சென்னையில் புதிதாக தொற்று பாதித்தவர்களின் எண்ணிக்கை 257 எனவும் கோவை மாவட்டத்தில் 514 எனவும் தெரிவிக்கப்பட்டுள்ளது.
அதேநேரம், `` கள்ளக்குறிச்சி, கிருஷ்ணகிரி, மயிலாடுதுறை, நாகை, நீலகிரி, பெரம்பலூர், திருப்பத்தூர், திருவள்ளூர், திருவண்ணாமலை, திருவாரூர், தூத்துக்குடி, விழுப்புரம், விருதுநகர், திண்டுக்கல் ஆகிய 14 மாவட்டங்களில் புதிய நோயாளிகளின் எண்ணிக்கை நேற்று முன்தினத்தைவிட சற்று அதிகரித்து இருக்கிறது" என்கிறார் விடுதலைச் சிறுத்தைகள் கட்சியின் பொதுச் செயலாளரும் நாடாளுமன்ற உறுப்பினருமான ரவிக்குமார்.
திருவண்ணாமலையில் பாதிப்பு ஏன்?

பட மூலாதாரம், Getty Images
தொடர்ந்து பிபிசி தமிழிடம் மேலதிக தகவல்களைப் பட்டியலிட்டவர் "ஊரடங்கில் தளர்வுகள் அறிவிக்கப்பட்டதும் மக்கள் நடமாட்டம் அதிகரிக்கத் தொடங்கிவிட்டது. நாட்டில் மிகவும் வேகமாகப் பரவும் திரிபாக டெல்டா திரிபு உள்ளது. இரண்டாம் அலைக்கு மிக முக்கியக் காரணமாக இந்த வைரஸ் திரிபு இருந்தது. மற்ற உருமாற்றங்களை எல்லாம் இது ஓரம்கட்டிவிட்டது. ஊரடங்கு கட்டுப்பாடுகள் காரணமாக சற்று குறைந்தது. தற்போது பேருந்து போக்குவரத்தும் தொடங்கிவிட்டது. திரை அரங்குகளையும் திறந்துவிட்டால் நிலைமை இன்னும் மோசமாகிவிடும்.
தமிழ்நாட்டில் அடுத்தடுத்து உள்ள திருவண்ணாமலை, விழுப்புரம், கள்ளக்குறிச்சி ஆகிய மாவட்டங்களில் தொற்று கூடியுள்ளது. திருவண்ணாமலையில் நேற்று முன்தினம் 125 ஆக இருந்த புதிய நோயாளிகளின் எண்ணிக்கை நேற்று 199 ஆக உயர்ந்துள்ளது.
விழுப்புரத்தில் 52 என்ற எண்ணிக்கையில் இருந்து 65 ஆகவும் , கள்ளக்குறிச்சியில் 99 என்ற அளவில் இருந்து 115 ஆகவும் அதிகரித்திருக்கிறது. இந்த 3 மாவட்டங்களையும் ஒருங்கிணைந்த முறையில் கவனித்து தொற்று அதிகரிக்காமல் தடுப்பதற்கு தமிழ்நாடு அரசு உரிய நடவடிக்கை எடுக்க வேண்டும்" என்று தெரிவித்தார்.
டெல்டா பிளஸ் அச்சம்
"இந்தியாவில் இதுவரை 45,000 மாதிரிகள் பரிசோதிக்கப்பட்டு 48 பேருக்கு டெல்டா பிளஸ் வைரஸ் தொற்று ஏற்பட்டு இருப்பது கண்டறியப்பட்டு இருக்கிறது. அவர்களில் 20 பேர் மகாராஷ்ட்ரா மாநிலத்தைச் சேர்ந்தவர்கள் எனவும் 10 பேர் தமிழ்நாட்டைச் சேர்ந்தவர்கள் எனவும் தகவல் வெளியாகியுள்ளது.
இந்தியாவில் டெல்டா பிளஸ் வைரஸால் பாதிக்கப்பட்டிருப்பவர்கள் அதிகமிருக்கும் மாநிலங்களாக மகாராஷ்டிராவும் தமிழ்நாடும் உள்ளன. டெல்டா பிளஸ் தொடர்பாக தமிழ்நாட்டில் எந்தளவுக்கு நடவடிக்கை எடுக்கப்பட்டுள்ளது எனத் தெரியவில்லை.
இந்திய சுகாதாரத்துறை அமைச்சகம் வெளியிட்ட தகவலில், `சென்னை, காஞ்சிபுரம், மதுரையில் டெல்டா பிளஸ் கண்டறியப்பட்டுள்ளது; அங்கு பாதிப்புள்ள இடங்களைக் கண்டறிந்து தடுக்க வேண்டும்' எனக் கூறியுள்ளது. டெல்டா பிளஸ் வைரஸ் தொற்று கண்டறியப்பட்ட சென்னை, காஞ்சிபுரம், மதுரை ஆகிய பகுதிகளில் ஒன்றிய அரசு அறிவுறுத்தியபடி கூடுதலான கட்டுப்பாடுகளைத் தமிழ்நாடு அரசு விதித்துள்ளதா என்பது தெரியவில்லை" என்கிறார் ரவிகுமார்.

பட மூலாதாரம், Getty Images
மேலும் "தமிழ்நாட்டில் இருந்து அனுப்பப்பட்ட ஆயிரம் மாதிரிகளில் 10 பேருக்கு டெல்டா பிளஸ் கண்டறியப்பட்டதாகக் கூறப்பட்டுள்ளது. ஆயிரத்துக்கு 10 என்றால் ஒரு லட்சம் பேருக்கு ஆயிரம் பேர் பாதிக்கப்பட்டுள்ளதாகவும் எடுத்துக் கொள்ளலாம். 45,000 மாதிரிகளில் நாம் கொடுத்தது வெறும் ஆயிரம் மாதிரிகள்தான். டெல்டா பிளஸ் பாதிப்பில் மகாராஷ்டிராவுக்கு அடுத்தபடியாக நாம் இருக்கிறோம். இதனால் என்ன மாதிரியான விளைவுகள் ஏற்படும் என தெரியவில்லை" என்கிறார்.
ஆய்வகம் அமைப்பதில் தாமதம் ஏன்?
தமிழ்நாட்டில் வைரஸின் மரபணு மூலக்கூறை (Genome sequencing) கண்டறியும் ஆய்வகங்கள் இன்னும் தொடங்கப்படாமல் உள்ளதே?" எனக் கேட்டோம்.
"ஆம். இதுதொடர்பாக சுகாதாரத் துறை அமைச்சரிடம் மனு கொடுத்துள்ளேன். இதனைத் தொடர்ந்து வலியுறுத்தி வருகிறேன். இதை செய்வதன் மூலம் கொரோனா வைரஸின் பல்வேறு திரிபுகளைக் கண்டறிந்து அதற்கேற்ப சிகிச்சையளிக்க முடியும்.
மூலக்கூறை கண்டறியும் ஆய்வகத்தை தொடங்காமல் தாமதப்படுத்துவது சரியானதல்ல. தற்போது வரையில் பெங்களூரு, புனே போன்ற நகரங்களுக்கு அனுப்பி பரிசோதனை முடிவுகளை பெற்று வருகின்றனர். இதற்கான உபகரணங்களை வாங்குவதற்கு 2 கோடி செலவாகும். விரைவில் தொடங்க உள்ளதாக அமைச்சர் தெரிவித்துள்ளார். இதுவே தாமதமான நடவடிக்கைதான்" என்கிறார்.
மேலும், "மூலக்கூறு ஆய்வகத்தைத் தொடங்குவது தொடர்பாக கடந்த ஏப்ரல் மாதமே சுகாதாரத்துறை செயலர் ராதாகிருஷ்ணனுக்கு மனு அனுப்பினேன். அவரிடம் இருந்து எந்தப் பதிலும் வரவில்லை. கடந்த ஆட்சியில் டெல்டா உருமாற்றத்தைக் கையாள்வதில் இருந்த மெத்தனம், இந்த ஆட்சியில் இருந்துவிடக் கூடாது.
பட மூலாதாரம், Getty Images
டெல்டா பிளஸ் வைரஸ் வேகமாகப் பரவக் கூடியது என்றும் நுரையீரலை நேரடியாக அதிகமாக பாதிக்கக் கூடியது என்றும் சொல்கின்றனர். தடுப்பூசியின் நோய் எதிர்ப்புத் திறனையும் தாண்டி பாதிக்கும் எனவும் மருத்துவ வல்லுநர்கள் தெரிவிக்கின்றனர். இப்படிப்பட்ட நிலையில் இதனை எவ்வாறு தடுப்பது என்பதை மிக முக்கியமான பிரச்னையாக அணுக வேண்டும்" என்கிறார்.
தொற்று அதிகரிப்பின் பின்னணி என்ன?
இதையடுத்து, தமிழ்நாடு பொது சுகாதாரத்துறை இயக்குநர் மருத்துவர் செல்வ விநாயகத்திடம் பிபிசி தமிழுக்காக பேசினோம். "ஒரு கூட்டத்தில் இருப்பதால் விரைவில் பேசுகிறேன்" என்றார்.
அடுத்ததாக, 14 மாவட்டங்களில் தொற்று பாதிப்பு கணிசமாக உயர்வது ஏன்? என தமிழ்நாடு அரசின் கொரோனா தடுப்புக் குழுவைச் சேர்ந்த பொது சுகாதார வல்லுநர் மருத்துவர் குழந்தைசாமியிடம் பிபிசி தமிழுக்காக பேசினோம்.
``மக்கள் நடமாட்டம் அதிகமுள்ள மாவட்டங்களில் தொற்று அதிகமாக உள்ளது. இதுவரையில் தொற்று குறைவாக இருந்த மாவட்டங்களில் பரவத் தொடங்கியிருக்கிறது. திருவண்ணாமலை உள்ளிட்ட சில மாவட்டங்களில் தற்போது அதிகரித்துள்ள எண்ணிக்கையை வைத்து எந்த முடிவுக்கும் வர முடியாது" என்கிறார்.
தொடர்ந்து பேசுகையில், "நீலகிரி, அரியலூர், திருவண்ணாமலை, ராமநாதபுரம் போன்ற மாவட்டங்களில் தொற்று பாதிப்பு குறைவாகவே இருந்து வந்தது. தற்போது அதிகரிப்பதை மிக உன்னிப்பாகக் கவனிக்க வேண்டும்.
இது இரண்டாம் அலையின் தொடர்ச்சியாகவும் மூன்றாம் அலைக்கான தொடக்கமாகவும் இருக்கலாம். சென்னையில் இருந்து நகர்ந்து ஒவ்வொரு இடங்களாக வைரஸ் பரவல் அதிகரித்தது. உதாரணமாக, சென்னையில் பாதிப்பு குறையத் தொடங்கும்போது கோவையில் அதிகரித்தது. சென்னைக்கு வந்த பிறகுதான் மதுரை, திருநெல்வேலி என தொற்று பரவல் விரிவடைந்தது.
அரசு என்ன செய்கிறது?

பட மூலாதாரம், Getty Images
கொரோனா வைரஸை பொறுத்தவரையில் எளிதாகப் பரவும் இடங்களில் அதிகமாகும். இதனை எதிர்கொள்ளும் வகையில் தமிழ்நாடு அரசு பல்வேறு நடவடிக்கைகளை எடுத்து வருகிறது. ஆக்சிஜன் உற்பத்தி, மருந்துகள், பாதுகாப்பு உபகரணங்கள் ஆகியவற்றில் போதிய கவனம் செலுத்தப்பட்டு வருகிறது.
தற்போது கர்ப்பிணித் தாய்மார்களுக்கும் கொரோனா தடுப்பூசி போடுமாறு கூறியுள்ளனர். இதில் பொதுமக்களின் ஒத்துழைப்பு தேவைப்படுகிறது. துணிக்கடை, நகைக்கடை, மளிகை அங்காடிகள், உணவு விடுதிகள் போன்ற மக்கள் கூடும் இடங்களில் இடைவெளியைக் கடைபிடிக்க வேண்டியது அவசியமானது.
முகக் கவசம் அணிவது தொடர்பாக போதிய விழிப்புணர்வு இருந்தாலும் கை கழுவுவது, காற்றோட்டமான சூழல், சானிடைசர் பயன்படுத்துவது போன்றவற்றில் அதிக கவனம் செலுத்த வேண்டும். தடுப்பூசி போடும் பணிகள் நிறைவடையும் வரையில் இதனைக் கடைபிடிக்க வேண்டியது அவசியம்.
கூடவே, மருத்துவமனைகளில் தேவையற்ற கூட்டம் கூடுவதைத் தவிர்க்க வேண்டும். அரசு மற்றும் தனியார் மருத்துவமனைகளில் கூட்டத்தைத் தடுக்கும் நடவடிக்கைகளைத் துரிதப்படுத்த வேண்டும். சிலர் துணிக் கடைகளுக்கு கைக் குழந்தைகளை அழைத்துச் செல்கின்றனர்.
அவர்கள் மூலம் வயதானவர்களுக்குப் பரவும் வாய்ப்புகள் அதிகம் உள்ளன. அரசு எவ்வளவு நடவடிக்கைகளை எடுத்தாலும் பொதுமக்களின் ஒத்துழைப்பு இல்லாமல் எதுவும் சாத்தியமில்லை" என்கிறார் மருத்துவர் குழந்தை சாமி.
விழுப்புரம், கள்ளக்குறிச்சிக்கு கூடுதல் கவனம் தேவை
இந்நிலையில், வியாழக்கிழமை மாலை நிலவரப்படி கொரோனா புதிய நோய்த்தொற்று எண்ணிக்கை 15 மாவட்டங்களில் நேற்று இருந்ததைவிட சற்று அதிகமாகி இருக்கிறது.
நேற்றுமுன் தினத்தைவிடப் புதிய நோயாளிகளின் எண்ணிக்கை குறைவாக இருந்த தஞ்சாவூர், சிவகங்கை, கடலூர், புதுக்கோட்டை, ராமநாதபுரம், தென்காசி, தேனி ஆகிய மாவட்டங்களில் இன்று சற்றே புதிய நோயாளிகளின் எண்ணிக்கை கூடியிருக்கிறது. தஞ்சாவூரில் மட்டும் 51 பேர் அதிகரித்து இன்றைய எண்ணிக்கை 248 ஆக உயர்ந்திருக்கிறது.
மதுரையில் நேற்று 68 புதிய நோயாளிகள் கண்டறியப்பட்டிருந்தனர். இன்று புதிய நோயாளிகளின் எண்ணிக்கை 94. காஞ்சிபுரத்தில் 68 ஆக இருந்தது இன்று 71 ஆக உயர்ந்திருக்கிறது, கரூரில் 32 ஆக இருந்தது இன்று 46 ஆக உயர்ந்திருக்கிறது.
விழுப்புரத்தில் இன்றும் புதிய நோயாளிகளின் எண்ணிக்கை சற்று கூடியிருக்கிறது. அதுபோலவே கள்ளக்குறிச்சியிலும் புதிய தொற்றின் எண்ணிக்கை உயர்ந்திருக்கிறது. இந்த இரு மாவட்டங்களிலும் கடந்த இரண்டு நாட்களாகத் தொடர்ந்து எண்ணிக்கை உயர்ந்து வருவது கவனத்திற்குரியதாகும். இப்படித் தொடர்ந்து 2 நாட்களாக பெரம்பலூர், திருப்பத்தூர், நீலகிரி ஆகிய மாவட்டங்களிலும் புதிய நோயாளிகளின் எண்ணிக்கை அதிகரித்து வருகிறது.
தமிழ்நாட்டில் மொத்தம் உள்ள ஆக்சிஜன் படுக்கையில் 47,669. அதில் இன்று நிரம்பி இருப்பவை 8153. ஐசியு படுக்கைகள் 9792 அதில் நிரம்பி இருப்பவை 3666.கொரோனா தொற்று மிகவும் குறைந்துள்ள இந்த நேரத்திலும் ஐசியு படுக்கைகள் 37% நிரம்பியிருப்பது கவலை தருகிறது.
"எல்லா மாவட்டங்களிலும் கொரோனா நோயாளிகளுக்கென ஒதுக்கப்பட்ட ஆக்ஸிஜன் அல்லாத படுக்கைகள் ஏராளமாக காலியாக இருக்கும் நிலையில் ( 26825) ஒப்பீட்டளவில் சிகிச்சை வசதிகள் குறைவாகக் கிடைக்கும் கொரோனா கேர் செண்டர்களில் இப்போதும் நோயாளிகளைத் தங்க வைப்பது ஏன்? அவர்களின் எண்ணிக்கை இன்று 5891 மட்டும்தான். அவர்களை மருத்துவமனைகளில் அனுமதித்து சிகிச்சை தந்தால் விரைவாக அவர்கள் குணமடைய ஏதுவாக இருக்கும். இதைத் தமிழ்நாடு அரசு பரிசீலிக்கவேண்டும்" என்கிறார் நாடாளுமன்ற உறுப்பினர் ரவிக்குமார்
பிற செய்திகள்:
சமூக ஊடகங்களில் பிபிசி தமிழ் :
- ஃபேஸ்புக் : பிபிசி தமிழ் ஃபேஸ்புக்
- டிவிட்டர் : பிபிசி தமிழ் ட்விட்டர்
- இன்ஸ்டாகிராம் : பிபிசி தமிழ் இன்ஸ்டாகிராம்
- யு டியூப் : பிபிசி தமிழ் யுடியூப்
































